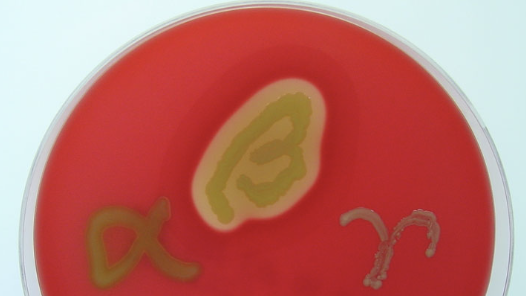
<p>beta-hemolysis (lysis of RBCs)</p>
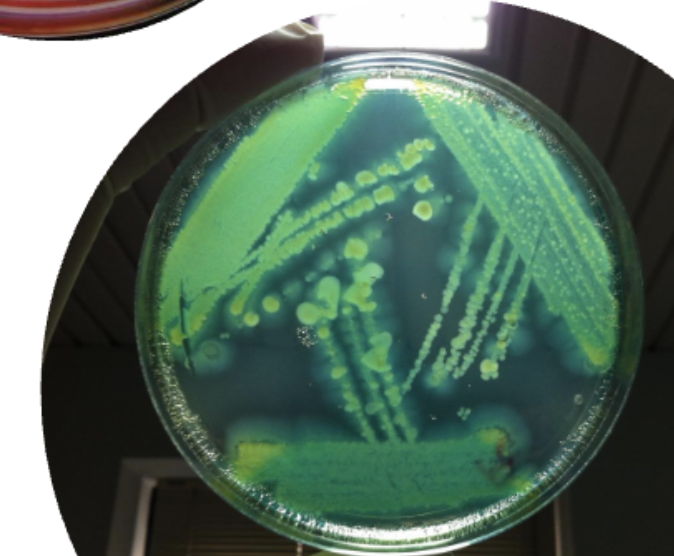
<ul><li><p>Smell: <strong>Grape or corn chips</strong></p></li><li><p>Texture: <strong>Metallic sheen</strong></p></li><li><p>Color: Pyocyanin and pyoverdin give <strong>GREEN</strong> color</p><ul><li><p>Pyorubin/melanin can also give <strong>BROWNish</strong> color too</p></li></ul></li></ul><p></p>

Lecture 21 - Pseudomonas
1/26
There's no tags or description
Looks like no tags are added yet.
Name | Mastery | Learn | Test | Matching | Spaced | Call with Kai |
|---|
No analytics yet
Send a link to your students to track their progress
27 Terms
What does Pseudomonas bacteria look like under the microscope?
Gram-neg rods (flagellated)
Motile
Main distinctive features of pseudomonas
Found in huge range of environments
Does not usually cause disease in humans
Frequently encountered as contaminants in clinical labs

When does Pseudomonas usually cause disease in humans?
Causes disease in immunocompromised individuals
Opportunistic pathogen
Key identification features for P. aeruginosa
Oxidase-pos
Non-lactose fermenting
Non-spore forming
Beta-hemolytic
Aerobic
If we were to grow P. aeruginosa on blood agar, what kind of patterns should we expect to see?
beta-hemolysis (lysis of RBCs)
T/F: P. aeruginosa can go dormant, is highly heat-resistant, and can withstand extreme heat, radiation, dehydration, and chemical damage
FALSE, it does not form endospores
T/F: If we were to place P. aeruginosa, in a non-aerobic environment, it would grow very well
FALSE, it is an aerobic bacteria
What are some “giveaways” of P. aeruginosa on agar?
Smell: Grape or corn chips
Texture: Metallic sheen
Color: Pyocyanin and pyoverdin give GREEN color
Pyorubin/melanin can also give BROWNish color too
What is a common activity that can cause P. aeruginosa disease in healthy individuals?
Contact with contaminated water through activities like swimming in pools or using hot tubs
Hot tub folliculitis
Swimmers ear

What are the treatments for P. aeruginosa diseases like hot tub folliculitis or swimmers ear?
Antibiotics
What are some diseases caused by P. aeruginosa (opportunistic)?
UTIs
Pneumonia
Wound infections (burn patients, diabetes)
Chronic pulmonary infection (cystic fibrosis)
How does mutations in the CFTR lead to cystic fibrosis?
The CFTR protein usually modulates flow of water and chloride out of cells into secretions
Mutations lead to:
Inefficient pumping causing THICK secretions
Thick mucus builds up in airway leading to chronic infection/inflammation

Treatments for cystic fibrosis
Antibiotic therapy
Pulmonary hygiene
Lung transplant
CFTR modulator therapy
Why is P. aeruginosa so antibiotic resistant?
P. aeruginosa can rapidly evolve within the lung environment, leading to phenotypically distinct isolates even from a single clone.
What are the main factors that allow P. aeruginosa to be so persistent (years or decades) and antibiotic resistant?
Biofilm formation
Mucoid phenotype
Genetic adaptability
P. aeruginosa biofilms are held together by a matrix made mainly of __________ (polysaccharides), proteins, and bacterial DNA/debris
alginate
Which of the following is NOT an advantage of biofilm formation?
A) Improves bacterial persistence
B) Protects bacteria from the immune system by inhibiting complement activation and reducing antibody opsonization
C) Enhances adherence to surfaces
D) Releases proteases for tissue destruction/invasion
D) Releases proteases for tissue destruction/invasion
Why do biofilms allow P. aeruginosa to be so antibiotic resistant?
Cells in the biofilm undergo gene expression changes
Have metabolically inactive cores that reduce antibiotic effectiveness
Contain dormant cells that can survive treatment and reseed the biofilm, allowing the community to persist like a “superorganism”.
What is the mucoid phenotype in P. aeruginosa?
Overproduction of alginate, forming a capsule around bacteria.

Which one leads to worse clinical outcomes: Biofilms or mucoid?
Mucoid phenotype
How does mucoid phenotype increase virulence?
Forms protected microcolonies
Binds some antibiotics
Shields bacteria from immune responses
T/F: Genetic differences among bacterial strains are greater than genetic differences among humans
TRUE
Role of single nucleotide polymorphisms (SNPs)
Can change the coding sequence of genes, alter protein function
SNPs are a large contributor to human (and bacterial) genetic variation
The concept of pan-genome is that some genes are ALWAYS found in an organism and some genes are VARIABLY found in an organism.
What is the difference if it is always present or variably present?
Always:
Core genome
Genes that are essential to that species
Define what the organism really is, genetically
Variably:
“Accessory genome”
Genes that may offer some advantages in some
situations (antibiotic resistance, metabolic genes, etc.)
Define what an organism can do.
T/F: The pan genome usually always consists of the core genome but the accessory genome can vary
FALSE, it comprises both the core and the entire accessory genome
The pan-genome is far (larger/smaller) than the genomic content of any single strain.
Larger
Antibiotic resistance genes, metabolic genes, and virulence islands make up a big fraction of the _____________ genome
accessory